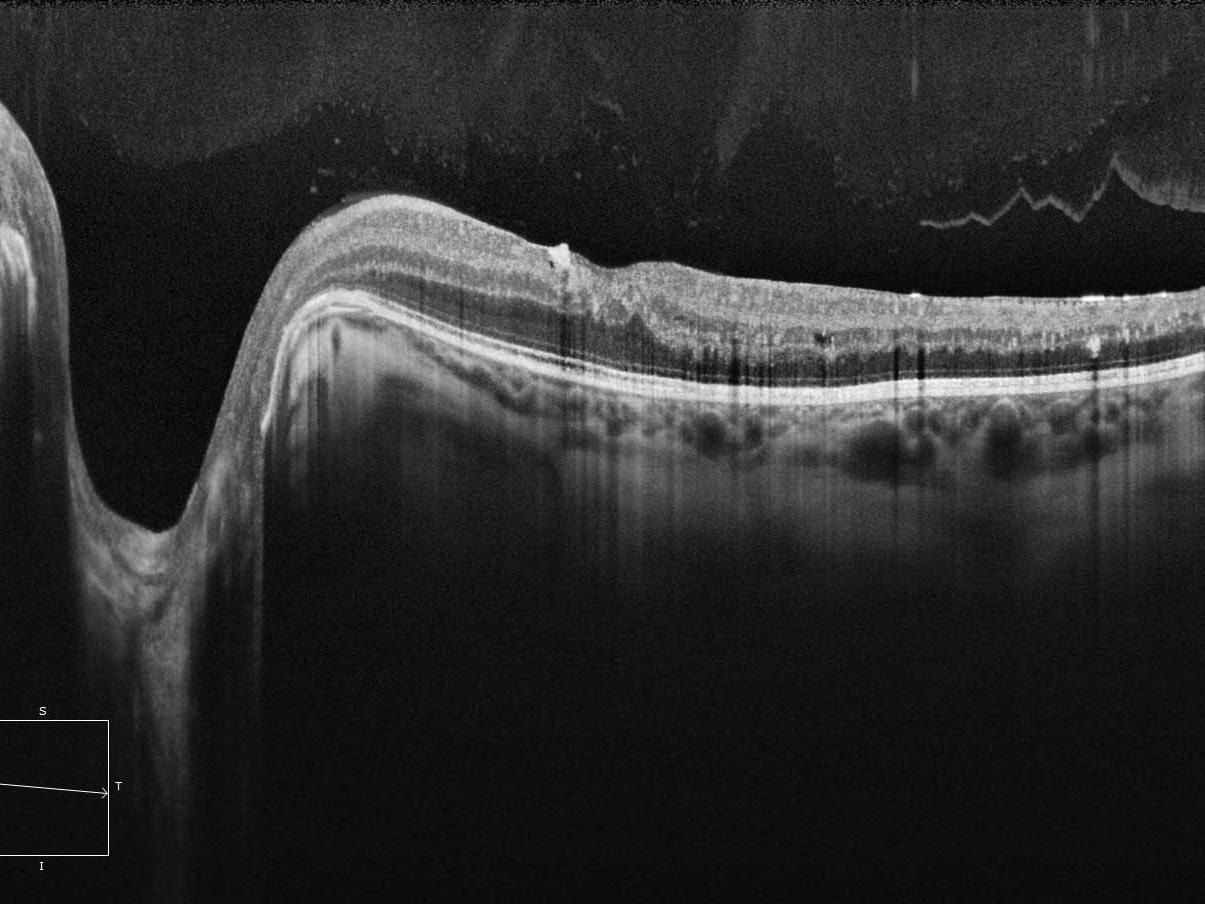

We offer a wide range of optical services at Hampton Park Optical.
If you have any queries or would like to book an appointment then please contact us and we will be more than happy to help.
We offer a wide range of optical services at Hampton Park Optical.
If you have any queries or would like to book an appointment then please contact us and we will be more than happy to help.

ZEISS Cirrus OCT Retinal Eye Check Latest in Eye Health Care
Measures the layers of the back of the eye to pick up early warning signs before they
affect your vision.
Southern Cross Medical Centre,
36-40 Stuart Ave Hampton Park 3976
P:03 9702 8187
sjhmbells@gmail.com
Open from 9am till 5pm Monday to Friday,
Saturday 9am to 1pm.
earlier or later by Appointment only.